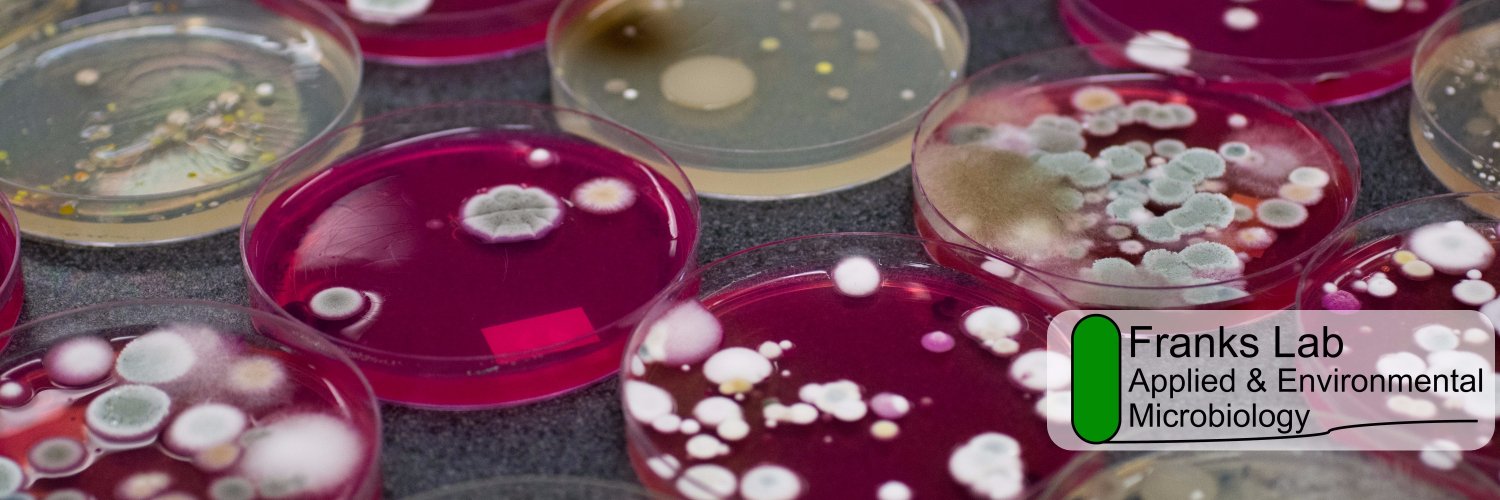
Applied and Environmental Microbiology Group banner

Applied and Environmental Microbiology Group
216 posts

Applied and Environmental Microbiology Group
@FranksMicrolab
led by Ashley Franks and Jen Wood - studying from gut heath to rainforest conservation, we think microbes are up to the task!











PhD study on soil carbon @UQ_News @CMMUQ1 @ANSTO @ausynchrotron. Apply now at graduate-school.uq.edu.au/phd-scholarshi…. DM me to find out more. Retweet please.

A huge congratulations to Dr Keaton Crosse @keaton_crosse and Matthew Brewer @MattBrewerMicro, for becoming our newest HDR completions! We are looking forward to seeing how you both shape the world with your science! @LTUresearchers



A huge congratulations to @JW_ilikedirt for winning the Jim Pittard award for her research on the role of microbial communities in a diverse range of ecosystems. Awarded by @AUSSOCMIC to an ECR Microbiologist for outstanding contributions to the field. @LTUresearchers @latrobe



















